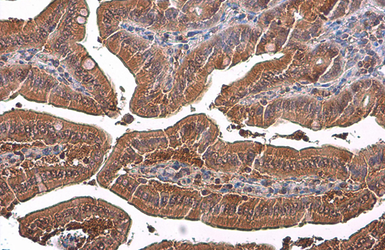

GAPDH antibody

GAPDH antibody detects GAPDH protein at endoplasmic reticulum, cytoplasm and nucleus by immunofluorescent analysis.Sample: HeLa cells were fixed in 4% paraformaldehyde at RT for 15 min.Green: GAPDH stained by GAPDH antibody (GTX100118) diluted at 1:500.Blue: Fluoroshield with DAPI (GTX30920).

The data was published in the journal PLoS One in 2015. PMID: 25738497

The data was published in the journal Front Endocrinol (Lausanne) in 2017. PMID: 29109696

The data was published in the journal Acta Neuropathol in 2019. PMID: 30874922

The data was published in the journal PLoS One in 2015. PMID: 25738497

The data was published in the journal Oncotarget in 2018. PMID: 29899821

The data was published in the journal PLoS One in 2015. PMID: 25811469

The data was published in the journal PLoS One in 2015. PMID: 25811469

The data was published in the journal Cell Adh Migr in 2019. PMID: 31240993

The data was published in the journal Oncotarget in 2016. PMID: 27034167

The data was published in the journal Biomolecules in 2019. PMID: 31505885

The data was published in the journal Virulence in 2018. PMID: 29338543

The data was published in the journal Cancers (Basel) in 2019. PMID: 30634502

The data was published in the journal Virulence in 2018. PMID: 29338543

The data was published in the journal Oncotarget in 2016. PMID: 27191263

The data was published in the journal Virulence in 2018. PMID: 29338543

The data was published in the journal Brain Behav in 2013. PMID: 24363972

The data was published in the journal Front Microbiol in 2019. PMID: 31969874

The data was published in the journal J Immunol Res in 2017. PMID: 29423418

The data was published in the journal J Cell Mol Med in 2020. PMID: 31821701

The data was published in the journal Cell Adh Migr in 2019. PMID: 31240993

The data was published in the journal PLoS One in 2015. PMID: 25928539

The data was published in the journal Oncotarget in 2018. PMID: 29899821

The data was published in the journal PLoS One in 2015. PMID: 25811469

The data was published in the journal Int J Mol Sci in 2018. PMID: 29518977

The data was published in the journal Oncotarget in 2018. PMID: 29899821

The data was published in the journal PLoS Pathog in 2019. PMID: 30742689

The data was published in the journal PLoS One in 2015. PMID: 25876076

The data was published in the journal Oncogenesis in 2015. PMID: 26690546

The data was published in the journal PLoS Pathog in 2019. PMID: 30742689

The data was published in the journal Oncoscience in 2016. PMID: 28105458

The data was published in the journal PLoS One in 2015. PMID: 25928539

The data was published in the journal Oncotarget in 2018. PMID: 29899821

The data was published in the journal Oncotarget in 2018. PMID: 29899821

The data was published in the journal J Cell Mol Med in 2020. PMID: 31821701

The data was published in the journal PLoS One in 2015. PMID: 25738497

The data was published in the journal Oncotarget in 2018. PMID: 29899821

The data was published in the journal Cancers (Basel) in 2019. PMID: 30634502

The data was published in the journal Cell Div in 2019. PMID: 31110557

The data was published in the journal PLoS Pathog in 2019. PMID: 30742689

The data was published in the journal Virulence in 2018. PMID: 29338543

The data was published in the journal Oncotarget in 2016. PMID: 27191263

The data was published in the journal J Immunol Res in 2018. PMID: 30410941

The data was published in the journal Oncotarget in 2016. PMID: 27034167

The data was published in the journal Oncotarget in 2016. PMID: 27191263

The data was published in the journal Oncotarget in 2016. PMID: 27034167

The data was published in the journal Oncotarget in 2018. PMID: 29899821

The data was published in the journal mSphere in 2019. PMID: 30814317

The data was published in the journal PLoS Negl Trop Dis in 2018. PMID: 29505577

The data was published in the journal J Hematol Oncol in 2019. PMID: 31324208

The data was published in the journal Int J Mol Sci in 2016. PMID: 26938532

The data was published in the journal Oncogenesis in 2015. PMID: 26690546

The data was published in the journal Aging Cell in 2020. PMID: 31833196

The data was published in the journal Oncogenesis in 2015. PMID: 26690546

The data was published in the journal Front Endocrinol (Lausanne) in 2017. PMID: 29109696

The data was published in the journal Nat Commun in 2020. PMID: 32358491

The data was published in the journal Int J Mol Sci in 2016. PMID: 26938532

The data was published in the journal Biomolecules in 2019. PMID: 31443530

The data was published in the journal J Int Soc Sports Nutr in 2015. PMID: 25792976

The data was published in the journal Cell Death Dis in 2013. PMID: 23788038

The data was published in the journal Biomolecules in 2019. PMID: 31443530

The data was published in the journal Biomolecules in 2019. PMID: 31443530

The data was published in the journal Cell Death Dis in 2013. PMID: 23788038

The data was published in the journal Biomolecules in 2019. PMID: 31443530

The data was published in the journal Biomolecules in 2019. PMID: 31443530

The data was published in the journal Breast Cancer Res in 2017. PMID: 29258605

The data was published in the journal Biomolecules in 2019. PMID: 31443530

The data was published in the journal PLoS One in 2014. PMID: 24551118

The data was published in the journal PLoS One in 2015. PMID: 26360058

The data was published in the journal PLoS One in 2014. PMID: 24551118

The data was published in the journal J Cell Mol Med in 2014. PMID: 24400868

The data was published in the journal J Cell Mol Med in 2014. PMID: 24400868

The data was published in the journal J Cell Mol Med in 2014. PMID: 24400868

The data was published in the journal PLoS One in 2015. PMID: 26360058

The data was published in the journal Evid Based Complement Alternat Med in 2012. PMID: 23024692

The data was published in the journal J Cell Mol Med in 2014. PMID: 24400868

The data was published in the journal J Hematol Oncol in 2018. PMID: 29458389

The data was published in the journal PLoS One in 2015. PMID: 26360058

The data was published in the journal PLoS One in 2015. PMID: 26360058

The data was published in the journal PLoS One in 2015. PMID: 26305546

The data was published in the journal Evid Based Complement Alternat Med in 2013. PMID: 24282433

The data was published in the journal J Biomed Sci in 2014. PMID: 25200553

The data was published in the journal J Biomed Sci in 2014. PMID: 25200553

The data was published in the journal Evid Based Complement Alternat Med in 2013. PMID: 23573126

The data was published in the journal Cell Discov in 2015. PMID: 27462424

The data was published in the journal Cell Discov in 2015. PMID: 27462424

The data was published in the journal Dis Model Mech in 2014. PMID: 24271779

The data was published in the journal Dis Model Mech in 2014. PMID: 24271779

The data was published in the journal J Biomed Sci in 2014. PMID: 25200553

The data was published in the journal Dis Model Mech in 2014. PMID: 24271779

The data was published in the journal J Biomed Sci in 2013. PMID: 24359494

The data was published in the journal PLoS Genet in 2015. PMID: 25760041

The data was published in the journal PLoS One in 2015. PMID: 25799508

The data was published in the journal Evid Based Complement Alternat Med in 2013. PMID: 23573126

The data was published in the journal Front Physiol in 2016. PMID: 27965586

The data was published in the journal PLoS One in 2016. PMID: 26863132

The data was published in the journal J Biomed Sci in 2013. PMID: 24359494

The data was published in the journal Front Physiol in 2016. PMID: 27965586

The data was published in the journal PLoS One in 2015. PMID: 25938237

The data was published in the journal PLoS One in 2015. PMID: 25938237

The data was published in the journal Physiol Rep in 2016. PMID: 27482075

The data was published in the journal PLoS One in 2015. PMID: 25938237

The data was published in the journal Stem Cells Transl Med in 2020.PMID: 31943851

The data was published in the journal Sci Rep in 2017.PMID: 28098200

The data was published in the journal Front Immunol in 2020.PMID: 32210961

The data was published in the journal Stem Cells Transl Med in 2020.PMID: 31943851

The data was published in the journal Front Immunol in 2020.PMID: 32210961

The data was published in the journal Front Immunol in 2020.PMID: 32210961

The data was published in the journal Front Immunol in 2020.PMID: 32210961

The data was published in the journal Stem Cell Res Ther in 2018.PMID: 29751772

The data was published in the journal PLoS One in 2016.PMID: 27023634

The data was published in the journal J Virol in 2016.PMID: 27489281

The data was published in the journal PLoS Biol in 2015.PMID: 26406915

The data was published in the journal PLoS One in 2019.PMID: 30893332

The data was published in the journal PLoS One in 2016.PMID: 27023634

The data was published in the journal Nat Commun in 2020.PMID: 32286300

The data was published in the journal PLoS One in 2016.PMID: 27383761

The data was published in the journal Cell Death Dis in 2019.PMID: 31427568

The data was published in the journal Stem Cell Res Ther in 2018.PMID: 29751772

The data was published in the journal PLoS One in 2016.PMID: 27023634

The data was published in the journal Oncotarget in 2016.PMID: 27564110

The data was published in the journal PLoS One in 2016.PMID: 27023634

The data was published in the journal Sci Rep in 2017.PMID: 28098200

The data was published in the journal PLoS One in 2016.PMID: 27023634

The data was published in the journal Int J Mol Sci in 2020.PMID: 32545770

The data was published in the journal Int J Mol Sci in 2020.PMID: 32545770

The data was published in the journal Sci Rep in 2017.PMID: 28098200

The data was published in the journal Nat Commun in 2020.PMID: 32286300

The data was published in the journal Sci Rep in 2017.PMID: 28098200

The data was published in the journal Mol Oncol in 2020.PMID: 32037723

The data was published in the journal Stem Cell Res Ther in 2018.PMID: 29751772

The data was published in the journal PLoS One in 2016.PMID: 27023634

The data was published in the journal Oncotarget in 2015.PMID: 25797272

The data was published in the journal BMC Cancer in 2018.PMID: 30594165

The data was published in the journal Stem Cell Res Ther in 2018.PMID: 29751772

The data was published in the journal Sci Rep in 2020.PMID: 32427884

The data was published in the journal Int J Mol Sci in 2020.PMID: 32545770

The data was published in the journal Oncotarget in 2015.PMID: 25797272

The data was published in the journal PLoS Biol in 2015.PMID: 26406915

The data was published in the journal PLoS Biol in 2015.PMID: 26406915

The data was published in the journal Front Aging Neurosci in 2014.PMID: 25136316

The data was published in the journal Sci Rep in 2017.PMID: 28098200

The data was published in the journal Int J Mol Sci in 2020.PMID: 32098449

The data was published in the 2014 in Alzheimers Res Ther. PMID: 25478031

The data was published in the 2019 in Cell Div. PMID: 31452676

The data was published in the 2019 in Cell Div. PMID: 31452676

The data was published in the 2020 in Sci Rep. PMID: 33177556

The data was published in the 2019 in Cell Div. PMID: 31452676

The data was published in the 2022 in Int J Mol Sci. PMID: 35328622

The data was published in the 2022 in Front Cell Dev Biol. PMID: 35309907

The data was published in the 2019 in Oncogene. PMID: 30792539

The data was published in the 2022 in FEBS Open Bio. PMID: 34856073

The data was published in the 2019 in Oncogene. PMID: 30792539

The data was published in the 2019 in Oncogene. PMID: 30792539

The data was published in the 2021 in Cancer Cell Int. PMID: 33926470

The data was published in the 2020 in Sci Rep. PMID: 32424165

The data was published in the 2021 in Eur Psychiatry. PMID: 33413711

The data was published in the 2022 in Biomedicines. PMID: 35203455

The data was published in the 2021 in Stem Cell Res Ther. PMID: 34020702

The data was published in the 2021 in Cancer Cell Int. PMID: 33926470

The data was published in the 2022 in Front Microbiol. PMID: 35572621

The data was published in the 2022 in Cell Death Dis. PMID: 35688824

The data was published in the 2022 in Cell Death Dis. PMID: 36435842

The data was published in the 2022 in Front Microbiol. PMID: 35572621

The data was published in the 2022 in Front Pharmacol. PMID: 35517780

The data was published in the 2022 in Front Pharmacol. PMID: 35517780

The data was published in the 2022 in Front Microbiol. PMID: 35572621

The data was published in the 2022 in Front Pharmacol. PMID: 35517780

The data was published in the 2022 in Pharmaceutics. PMID: 35456673

-
HostRabbit
-
ClonalityPolyclonal
-
IsotypeIgG
-
ApplicationsWB ICC/IF IHC-P IP
-
ReactivityHuman, Mouse, Rat, Zebrafish, Rabbit, Drosophila, Bovine, Dog, Hamster, Chicken, Pig, Monkey, Caenorhabditis elegans, E. coli, Mosquito, Nematode, Pika, Plant, Fish, Bacteria, Insect, milkfish